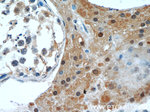
GSNOR/ADH5 Antibody in Immunohistochemistry (Paraffin) (IHC (P))

Search
Proteintech
GSNOR/ADH5 Monoclonal Antibody (5E6E2)
{{$productOrderCtrl.translations['antibody.pdp.commerceCard.promotion.promotions']}}
{{$productOrderCtrl.translations['antibody.pdp.commerceCard.promotion.viewpromo']}}
{{$productOrderCtrl.translations['antibody.pdp.commerceCard.promotion.promocode']}}: {{promo.promoCode}} {{promo.promoTitle}} {{promo.promoDescription}}. {{$productOrderCtrl.translations['antibody.pdp.commerceCard.promotion.learnmore']}}
产品信息
66193-1-IG
种属反应
宿主/亚型
分类
类型
克隆号
抗原
偶联物
形式
浓度
纯化类型
保存液
内含物
保存条件
运输条件
产品详细信息
Immunogen sequence: MANEVIKCK AAVAWEAGKP LSIEEIEVAP PKAHEVRIKI IATAVCHTDA YTLSGADPEG CFPVILGHEG AGIVESVGEG VTKLKAGDTV IPLYIPQCGE CKFCLNPKTN LCQKIRVTQG KGLMPDGTSR FTCKGKTILH YMGTSTFSEY TVVADISVAK IDPLAPLDKV CLLGCGISTG YGAAVNTAKL EPGSVCAVFG LGGVGLAVIM GCKVAGASRI IGVDINKDKF ARAKEFGATE CINPQDFSKP IQEVLIEMTD GGVDYSFECI GNVKVMRAAL EACHKGWGVS VVVGVAASGE EIATRPFQLV TGRTWKGTAF GGWKSVESVP KLVSEYMSKK IKVDEFVTHN LSFDEINKAF ELMHSGKSIR TVVKI (1-374 aa encoded by BC014665)
靶标信息
This gene encodes a member of the alcohol dehydrogenase family. Members of this family metabolize a wide variety of substrates, including ethanol, retinol, other aliphatic alcohols, hydroxysteroids, and lipid peroxidation products. The encoded protein forms a homodimer. It has virtually no activity for ethanol oxidation, but exhibits high activity for oxidation of long-chain primary alcohols and for oxidation of S-hydroxymethyl-glutathione, a spontaneous adduct between formaldehyde and glutathione. This enzyme is an important component of cellular metabolism for the elimination of formaldehyde, a potent irritant and sensitizing agent that causes lacrymation, rhinitis, pharyngitis, and contact dermatitis. The human genome contains several non-transcribed pseudogenes related to this gene.
仅用于科研。不用于诊断过程。未经明确授权不得转售。
生物信息学
蛋白别名: ADH-B2; alcohol dehydrogenase (class III), chi polypeptide; Alcohol dehydrogenase 2; Alcohol dehydrogenase 5; Alcohol dehydrogenase B2; Alcohol dehydrogenase class chi chain; Alcohol dehydrogenase class-3; Alcohol dehydrogenase class-III; class III alcohol dehydrogenase, chi subunit; epididymis secretory sperm binding protein Li 60p; FALDH; FDH; formaldehyde dehydrogenase; Glutathione-dependent formaldehyde dehydrogenase; GSH-FDH; S-(hydroxymethyl)glutathione dehydrogenase; S-nitrosoglutathione reductase
基因别名: Adh-2; ADH-3; Adh-5; Adh2; Adh3; ADH5; ADHX; FALDH; FDH; GSH-FDH; GSNOR; HEL-S-60p
UniProt ID: (Human) P11766, (Rat) P12711, (Mouse) P28474
Entrez Gene ID: (Human) 128, (Pig) 100513555, (Rat) 100145871, (Mouse) 11532